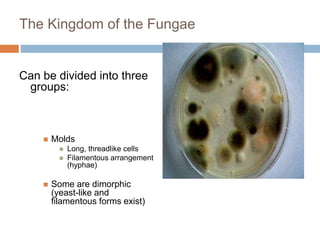

The Long Thread Like Branching Cells of Molds Are Called
These bacteria are seen as long strands under the microscope. It grows swellings on its surface called buds which then become separate cells.
Solved Question 12 Filamentous Fungi Are Called Chegg Com
Mycelium- Tangled mass of hyphae is called mycelium.
. When a eukaryotic cell is not undergoing mitosis the DNA and its associated proteins appear as a visible thread-like mass called the proteins associated with DNA in the nucleus Histones are mostly polysaccharide The eukaryotic cells glycocalyx is All of the choices are correct. Filaments that are hair-like or thread-like branching cylindrical tubules made up of fungal cells from end-to-end. The cells of hyphae have thin cell walls made up of chitin.
Produces a tubular thread like structure called hypha. Fungi grow by adding new cells to the tip of the hyphae. Nucleus mitochondria endoplasmic reticulum lysosomes.
Examples of fungi are yeasts rusts stinkhorns puffballs truffles molds mildews and mushrooms. Muxakara and 3 more users found this answer helpful. - Answers Hyphae singular.
The long thread-like branching cells of mold are called Hyphae The eukaryotic cell organelle that most resembles a bacterial cell is the Mitochondria Long threadlike fungal cells are called Fungi Intertwined mass of hypha are called Mycelium Site for ribosomal rna synthesis is Nucleolus. Tend to be dry and fuzzy. The network of hyphae is called mycelium.
Hyphae may be septate or. What are three examples of fungi. Structure and morphology of hyphae vary with the group of fungi.
Mycelium is to a. Like plants and animals fungi are eukaryotic multicellular organisms. Grow and extend from the tubule tips.
They are also present in water treatment areas. Up to 24 cash back Molds. What do the terms mean coenocytic hyphae.
Mycelium Mass of branching intertwined hyphae a. Most fungi obtain nutrients from dead plants and animals. The various types of microorganisms include bacteria algae protozoa helminths and fungi.
Mycelium is the vegetative part of a fungus consisting of a branching thread-like collection of cells called hyphae. The long thread-like branching cells of molds are called A. Hyphae are branch-like filaments that typically grow from fungi such as molds.
Filamentous bacteria are those bacteria that produce long mesh-like filament by growing end to end. Mycelium has a complex network structure that absorbs and distributes nutrients throughout its environment. Hyphae represent the vegetative structure of a fungus.
The woven intertwining mass of hyphae that makes up the body or colony of a mold. Fungi are long branching filaments or. See also what is the largest mountain range in the us.
Instead of having roots and leaves molds grow as thread-like filaments called hyphae. What are the long thread-like branching cells of molds called. What are the long thread-like branching cells of molds called.
The bodies of the fungi consist of long slender thread-like structures called hyphae. Hyphae singular hypha are the fungal cells arranged in end to end fashion to form threadlike filaments. There is another entity which is non cellular parasitic protein coated genetic element that infect host cell causing harm which are studied alongside the above microbes as they are capable of infecting the microbes as well and these are termed as viruses.
The long thread-like branching cells of molds are called Hyphae Hyphae In humans helminths generally infect the Digestive tract Protozoan cysts are Primary form of replication Primary form of replication Eating undercooked meat can lead to food-borne disease via helminthic infection. A hypha plural hyphae from Greek ὑφή huphḗ web is a long branching filamentous structure of a fungus oomycete or actinobacterium. Coenocytic hyphae are nonseptate also called aseptate meaning they are one long cell that is not divided into compartments.
Long threadlike cells found in the bodies of filamentous fungi or molds. The bodies of the fungi consist of long slender thread-like structures called hyphae. 31 rows The long thread-like branching cells of molds are called.
Their cells are long and thread-like and connected end-to-end as you can see in the picture belowBecause of this diffuse association of their cells the body of the organism is given the special name. In most fungi hyphae are the main mode of vegetative growth and are collectively called a. Fungi producing mycelia are called molds or filamentous fungi.
Unlike these other groups however fungi are composed of filaments called hyphae. Vegetative Mycelium- hyphae that penetrate the. Conidiophores pseudohyphae hyphae.
Can be observed microscopically via KOH wet mount LPCB Scotch Tape Method Sandwich Method Slide Method or Tease Mount. The network of hyphae is called mycelium. What is the common host for Taenia solium.
Question 42 0615 out of 0615 points The long thread-like branching cells of mold are called. These bacteria are present in sludge areas for better settling. The long threadlike branching cells of molds are called.
Home Study Guides Science Math and Arithmetic History Literature and Language Technology Health.
Solved Question 12 Filamentous Fungi Are Called Chegg Com
Comments
Post a Comment